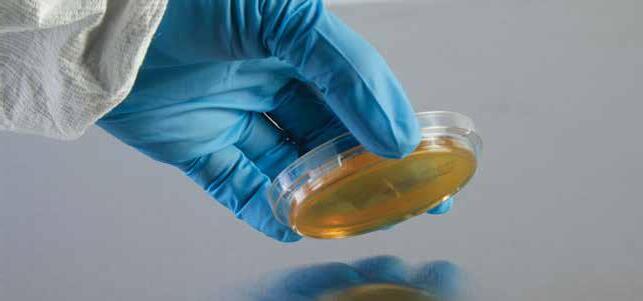
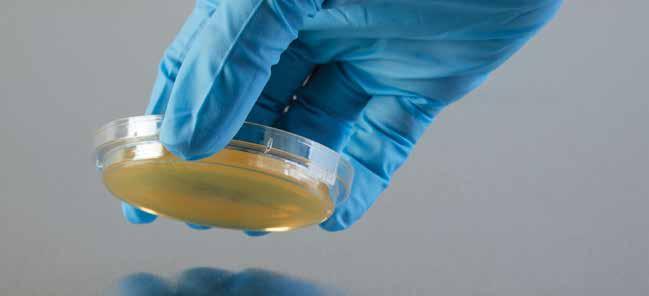
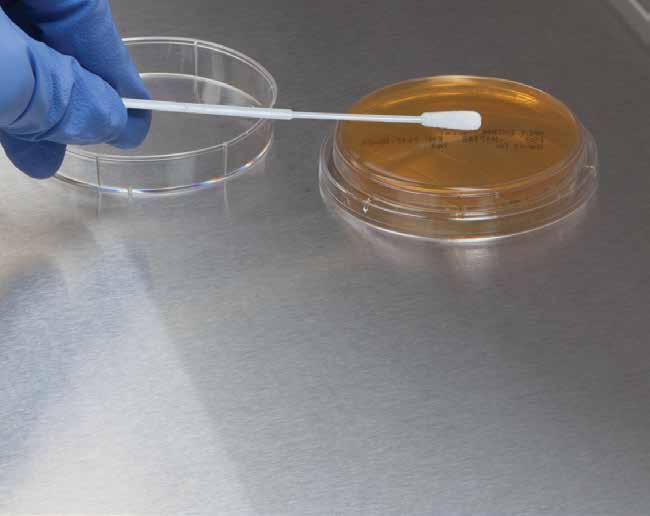

ASEPTIC TESTING and ENVIRONMENTAL MONITORING








![]()








Test Media - Contains Tryptic Soy Broth to encourage bacterial growth.
Note - Additional materials required to perform each test.
Category 1 CSP Media-Fill Test Kit
Includes:
- (12) 10mL Sterile Vials containing 5mL test media
- (3) 50mL Sterile Vials (empty)
- (1) Whirl-Pak® Bag
- (1) Results Log Sheet
Category 2 CSP Media-Fill Test Kit
Includes:
- (3) 50mL Vials containing test media
- (6) 50mL Sterile Vials (empty)
- (3) 10mL Sterile Vials (empty)
- (1) Whirl-Pak® Bag
- (1) Results Log Sheet
Category 3 CSP Media-Fill Test Kit
Includes:
- (1) 3 gram Vial containing test media
- (9) 10mL Sterile Vials (empty)
- (1) Whirl-Pak® Bag
- (1) Results Log Sheet
CSP Low Complexity Kit
Includes:
- (1) 100mL TSB Serum Vial
- (3) 20mL Sterile Serum Vials (empty)
- (1) Whirl-Pak® Bag
- (1) Results Log Sheet
CSP Medium Complexity Kit
Includes:
- (1) 1,000mL TSB Dual Port Bag (filled 700mL)
- (6) 100mL Sterile Dual Port Bags (empty)
- (6) 20mL Sterile Serum Vials (empty)
- (1) Whirl-Pak® Bag
- (1) Results Log Sheet
CSP High Complexity Kit
Includes:
- (1) 125mL TSB Non-sterile Powder (3 gram filled)
- (9) 20mL Sterile Serum Vials (empty)
- (1) Whirl-Pak® Bag
- (1) Results Log Sheet









DIY Convenience - Create your own media fill challenge for up to 5 technicians by choosing the components that most closely represent your most complex procedure as required by USP <797>.
Includes:
- (5) 100mL TSB Media Bag
- (5) 3mL TSB Ampules (dyed red)
- (5) 20mL Serum Needle Port Septum Vials
USA HCL Item # Description ü G 19873 Media Test Kit, Multi-Tech
DIY Convenience - Use a la carte items to create your own media fill challenge and match your most complex procedure as required by USP <797>. Tests allow users to document correct personnel technique and effective environmental control for the preparation of compounded sterile products.
Detect Microorganisms - IV bags contain TSB, which is a growth medium for bacteria and microbes and helps detect evidence of a wide variety of microorganisms. Each bag includes a needle port and spike port.
High Quality Materials - Glass vials are filled with TSB and sealed with a chlorobutyl stoppers and blue plastic caps.
20101 - 20ml vials filled with 15ml of TSB
20201 - 100ml vials filled with 100ml of TSB
Empty Serum Vials
Sterile Container - Sterile empty vial with rubber stopper and aluminum ring. Vials are not FDA registered and are not appropriate for medication storage.
Lifelike Simulation - Glass ampules are filled with red TSB to simulate commonly used chemotherapy agents. Protect against cuts and contamination with Disposable Ampule Breakers (10273). USA HCL Item # Description
ü A 19861 TSB IV Bags for Media Test, 100mL 10
ü B 19862 TSB IV Bags for Media Test, 700mL 5 ü C 20101 TSB Needle Port Septum Vials, 15mL 10
ü D 20102 TSB Needle Port Septum Vials, 100mL 10
ü E 19895 Empty Serum Vials for Media Test, 20mL 10
ü F 19863 Empty Serum Vials for Media Test, 100mL 10
ü G 20100 Red Dyed TSB Ampules, 3mL 20
ü ü H 10273 Disposable Ampule Breakers 100

Irradiated SabDex Agar
Contact Plates, 65mm
Media - Irradiated Sabouraud Dextrose Agar with Lecithin and Tween® 80 is recommended for the detection and enumeration of yeasts and fungi from environmental sources in a cleanroom setting.
Terminal Irradiation - Validated for a Sterility Assurance Level (SAL) of 10-6. Certificate of Analysis available upon request.
Room Temperature Storage - Terminally irradiated plates do not require refrigeration.
Molded Grid - Each plate has a molded grid to aid in counting microorganisms.
Expiration - Contact plates have a 30-day expiration.
Note - This temperature sensitive product will ship via UPS or FedEx Next Day. Product ships Monday - Thursday only.
Quantity - 10 per package; triple bagged; 2 nylon inner bags; 1 outer Mylar® heat-sealed bag with easy-tear notch
Dimensions - 15mm H x 65mm Dia.
Media - Irradiated Tryptic Soy Agar with Lecithin and Tween® 80 is recommended for use as a general growth medium for establishing microbiological trends, alerts and action levels in biologically controlled environments.
Terminal Irradiation - Validated for a Sterility Assurance Level (SAL) of 10-6. Certificate of Analysis available upon request.
Room Temperature Storage - Terminally irradiated plates do not require refrigeration.
Molded Grid - Each plate has a molded grid to aid in counting microorganisms.
20939 Only - Media is tinted red for easy identification.
Expiration - Contact plates have a 30-day expiration.
Note - This temperature sensitive product will ship via UPS or FedEx Next Day. Product ships Monday - Thursday only.
Quantity - 10 per package; triple bagged; 2 nylon inner bags; 1 outer Mylar® heat-sealed bag with easy-tear notch
Dimensions - 15mm H x 65mm Dia.
ü A 20938 Irradiated Tryptic Soy Agar Contact Plates, 65mm
ü B 20939 Irradiated Tryptic Soy Agar Contact Plates, Red Tinted, 65mm 10

These plates can be used with air samplers!
Detect Fungus - Quick, efficient method to test for mold and fungal growth in cleanroom areas. After compounding, swab surface and inoculate the plate, twist to lock, then incubate to gather results.
Ingredients - Plastic plate is filled with Malt Extract Agar (used to grow fungi, mold and yeast), Lecithin and Tween® (neutralizing agents that prevent growth interference from cleaning and disinfecting agents).
Expiration - Contact Plates have a 30-day expiration.
Note - This temperature sensitive product will ship via UPS Next Day or FedEx Next Day. Product ships MondayThursday only. Refrigerate immediately upon arrival.
Dimensions - 15mm deep x 60mm Dia


Monitor Bacterial Growth - Easily determine the efficiency of cleaning programs and aseptic techniques by monitoring the growth of bacterial colonies on incubated samples.
Ingredients - Tryptic Soy-based media is sterilized, then aseptically filled in an environmentally controlled room using automated equipment.
Expiration - Contact Plates have a 30-day expiration. This temperature sensitive product will ship via UPS Next Day or FedEx Next Day. Product ships Monday-Thursday only. Refrigerate immediately upon arrival.
Dimensions - 15mm deep x 60mm Dia.






Avoid Clutter - Stack and organize up to 42 petri dishes in this autoclavable polypropylene rack. Divider provides space for labeling.
Easily Access Contents - Slots allow for easy removal of plates while stacked.
Compatible - Fits inside these incubators (sold separately): 19996 - SureTemp™ Digital Incubator, 40L, Heat Only 20993 - SureTemp™ Digital Incubator, 70L, Heat Only
Assembly - Rack ships flat; some assembly required.
Versatile - Organize, batch, transport, refrigerate and incubate contact plates.
Monitor Progress - Wire design allows contents to be easily viewed throughout incubation.
Maximize Space - Racks hold 60 plates; 10 plates and lids per column. Each end has labeling space and racks can be stacked.
Compatibility:
21067 - 19996 SureTemp™ Digital Incubator 40L; 20993 SureTemp™ Digital Incubator 70L
21068 - 20993 SureTemp™ Digital Incubator 70L
Durable - Racks are made of thermoplastic coated polymer steel wire that is chemical and corrosion resistant; steam autoclavable at 250º F.





Hands-on Learning - Training and certification program educates participant(s) about the proper techniques and risks associated with handling cytotoxic drugs.
Multi-Use - 1 kit can be used to train 1 user multiple times or 5 separate users.
Kit Includes:
- (5) 50mg Fluorescein Sodium Salt
- (5) 3mL Fluorescein Solution 0.05%
- Recording log
Expiration - Chemo Training Kits have a 60-day expiration.

Promote Proper Hygiene - Disposable plastic fingernail picks help achieve compliance with USP <797> requirements for proper hand hygiene. Designed for use prior to surgical hand antisepsis.

Quantity - 150 per pack; 6 packs per case; 900 picks total

Convenient - Touchless dispenser encourages the use of hand scrub to help minimize the spread of infection. Designed for use with 19777 Waterless Surgical Scrub Gel. Side label provides instructions for proper cleaning technique.
Secure - LOCK OR NOT™ Technology allows users to lock the dispenser using the included key and avoid tamper or gel refill removal.
Durable - Sturdy plastic housing features a clear viewing window and indicator light that signals when refill is required. Requires 4 D batteries, not included.
Monitor Use - Works with GOJO® SMARTLINK™ Hand Hygiene Technology, which allows users to monitor staff compliance by turning real-time data into actionable information.

Active Ingredient - 70% Ethyl Alcohol
Follow Protocol - Pair with Nail Picks (20235) to meet proper hand hygiene protocol.
Persistent Activity - Alcohol-based surgical scrub formula kills microorganisms instantly and provides persistent activity to protect compounded sterile preparations from potentially harmful microbial exposure.
Compatible - Safe for use with latex, neoprene and polyisoprene gloves.
Eco-Friendly - Smart Flex™ PET bottle uses 30% less material than HDPE. Built-in technology prevents bottle from collapsing during use. use with the nail picks over there on page 12.






Operating Temperature Range - Ambient +5° to 75°C
Improve Accuracy - SureCheck™ technology allows users to set and monitor air temperature throughout incubation to determine that set points were met. User-set intervals allow users to record temperatures as often as every 60 seconds. Use a flash drive (not included) to download data points for easy record keeping.
Dual-Convection Technology - Choose between Mechanical Convection Mode for exceptional temperature uniformity or Gravity Convection Mode for longer incubations where airborne contamination or drying of samples may be an issue.
Storage Options - Includes 2 shelves; can accommodate up to 8. Additional shelves available through our Resource Group.
Operating Temperature Range:
20910 - 15°C below ambient to 60°C
21088 - 0ºC to 60ºC
19702 - Ambient 5°C to 60°C
Dual Functioning - Heats and cools (20910 and 21088 only) to meet a wider range of regulations.
Easy to Use - Automatic operation and digital display allow users to confidently choose their desired temperature with peace-of-mind monitoring. Features a large LED control panel that displays chamber temperature.
Small Footprint - Compact units (20910 and 19702 only) have generous interiors; all units have 2 adjustable shelves. An internal outlet powers small instruments and minimizes cord clutter outside the units.


A
B
C





